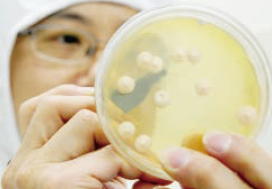

Os nossos marcos

Estabelecimento de filiais na Argélia e no Brasil, e complementa??o da expans?o do produto levedura no exterior.

Foram concluídos e postos em funcionamento projectos-chave como o parque industrial Angel Biotechnology e o parque industrial Angel Health Food.

Free Trade Zone Company criada, principalmente envolvida na importa??o e exporta??o alfandegária, transforma??o, I&D e comércio eletrónico transfronteiri?o.

Entrada em funcionamento da linha de produ??o de extrato de levedura no Egipto.

Início da produ??o da fábrica de levedura em Dankov, Rússia.

Início da produ??o da fábrica de levedura em Beni Suef, Egipto; cria??o do Departamento de Enzimas Especiais.

Cria??o do departamento de fabrico de cerveja e biocombustíveis.

Cria??o do Departamento de Nutri??o Microbiana.

Cria??o dos departamentos de extractos de levedura e de nutri??o animal.

Cria??o do Centro Tecnológico de Panifica??o e Confeitaria Chinesa.

2000 A Angel Yeast Co., Ltd. é cotada na Bolsa de Valores de Xangai. Foi criado o Departamento de Exporta??o para explorar o mercado internacional.

Hubei Angel Biotechnology Group Co.

A expans?o da primeira fábrica de levedura foi concluída, e a capacidade de produ??o foi duplicada para 4.000 toneladas.

Come?a a constru??o do Projeto Nacional de Base Experimental de Levedura e nasce a Angie's Yeast.

Estabelecimento de filiais na Argélia e no Brasil, e complementa??o da expans?o do produto levedura no exterior.

Foram concluídos e postos em funcionamento projectos-chave como o parque industrial Angel Biotechnology e o parque industrial Angel Health Food.

Free Trade Zone Company criada, principalmente envolvida na importa??o e exporta??o alfandegária, transforma??o, I&D e comércio eletrónico transfronteiri?o.

Entrada em funcionamento da linha de produ??o de extrato de levedura no Egipto.

Início da produ??o da fábrica de levedura em Dankov, Rússia.

Início da produ??o da fábrica de levedura em Beni Suef, Egipto; cria??o do Departamento de Enzimas Especiais.

Cria??o do departamento de fabrico de cerveja e biocombustíveis.
Cria??o do Departamento de Nutri??o Microbiana.

Cria??o dos departamentos de extractos de levedura e de nutri??o animal.

Cria??o do Centro Tecnológico de Panifica??o e Confeitaria Chinesa.

2000 A Angel Yeast Co., Ltd. é cotada na Bolsa de Valores de Xangai. Foi criado o Departamento de Exporta??o para explorar o mercado internacional.

Hubei Angel Biotechnology Group Co.

A expans?o da primeira fábrica de levedura foi concluída, e a capacidade de produ??o foi duplicada para 4.000 toneladas.

Come?a a constru??o do Projeto Nacional de Base Experimental de Levedura e nasce a Angie's Yeast.

